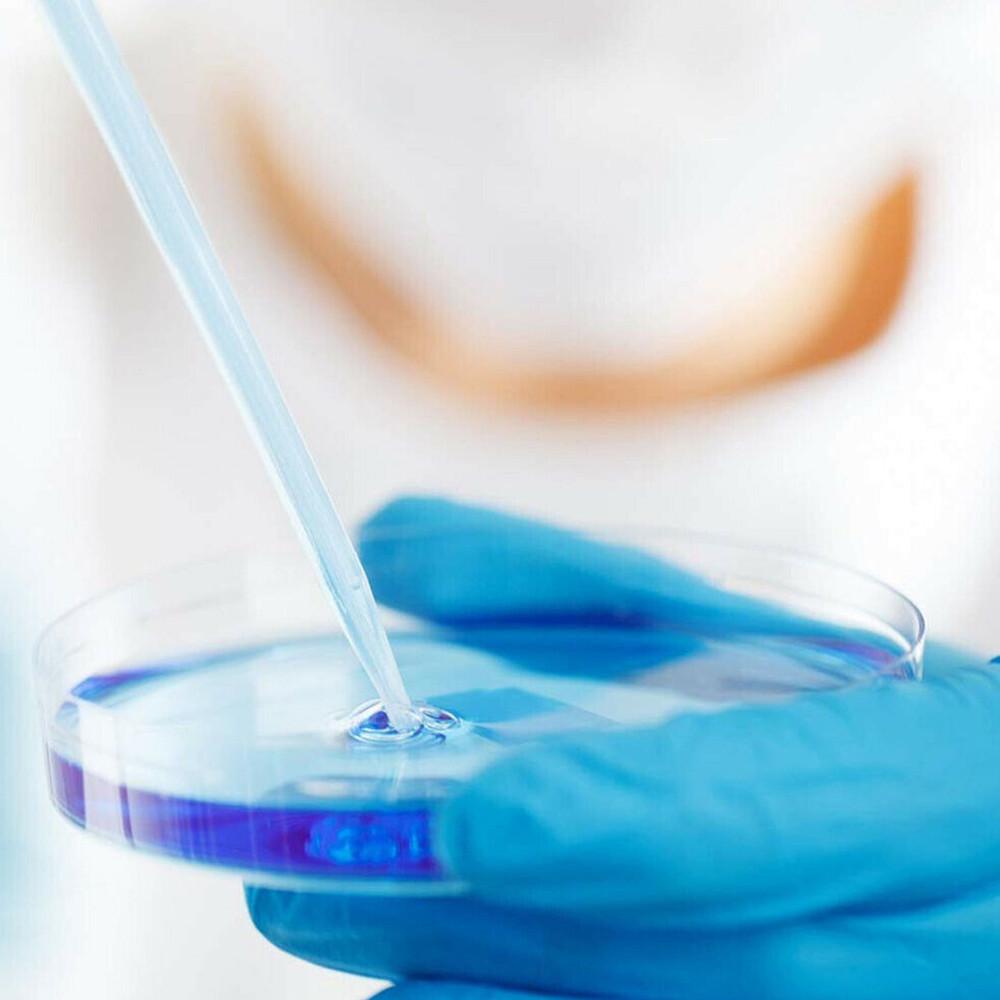
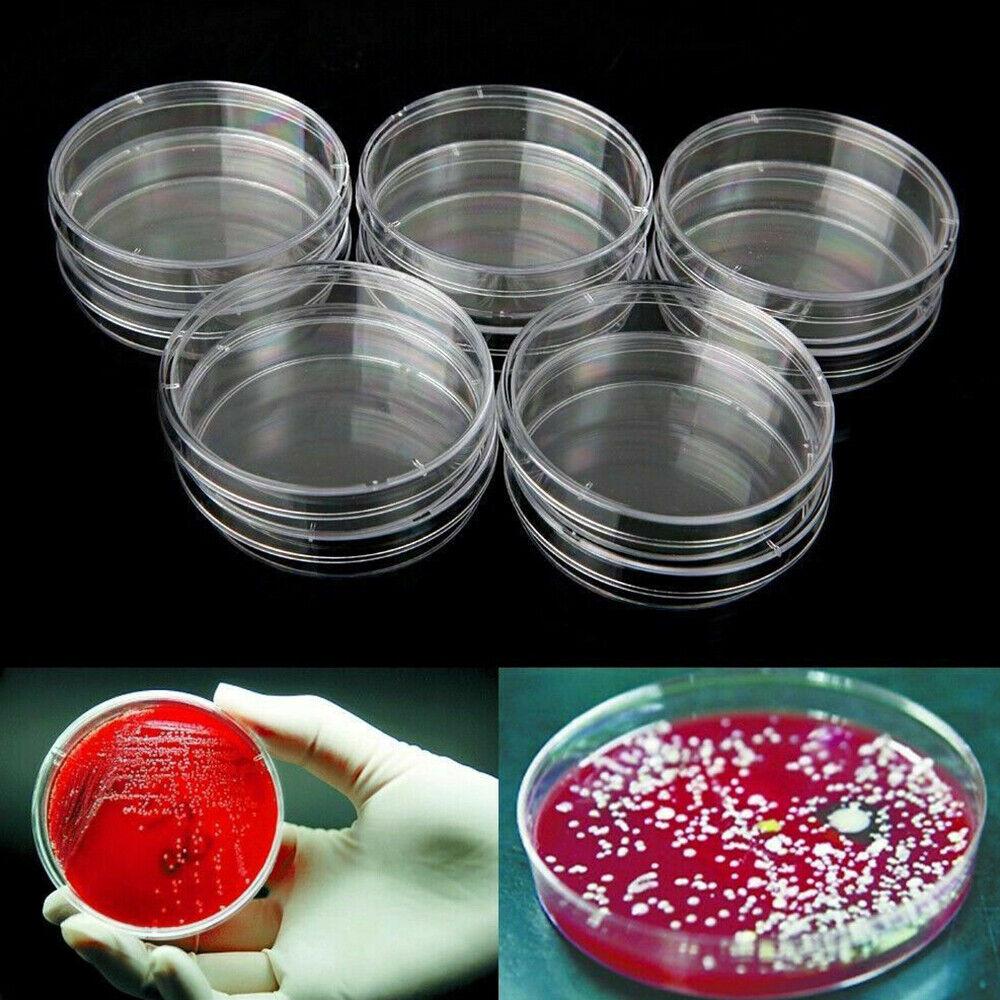

Description
20PCS/pack Plastic Petri Dishes With Lid 90x 15mm Polystyrene New AU
Description:
100% brand new and high quality
Perfect for laboratory analysis for medical, biological, scientific research and other activities, suitable for generaltraining.
Transparent,convenient,firm,use efficiency.
Culture For fungi, bacteria, and other microorganisms
Used in the surface smooth and highly uniform, automatic dispenser can be a good implementation of the operation
Deep hole bacteria Petri dish allows longer incubation period
Package Included:
20x Petri Dishes
Additional information
| Brand | Unbranded |
|---|